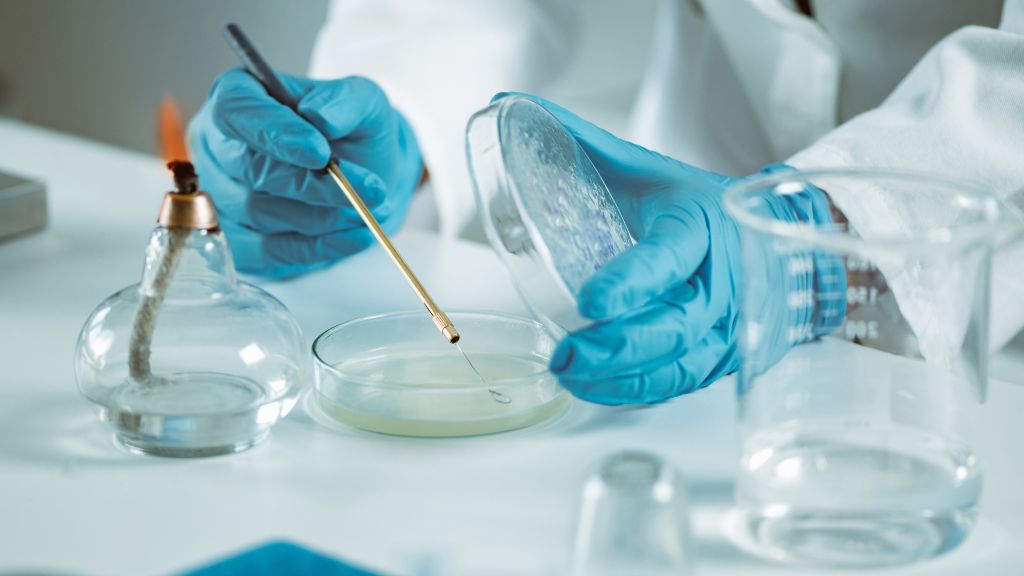
exame toxicológico

O exame toxicológico é uma ferramenta essencial para a identificação de substâncias químicas presentes no organismo humano. Com a crescente preocupação com a segurança viária e a renovação da CNH, esse tipo de exame tem ganhado destaque.
Neste artigo, vamos explorar em detalhes o que é exame toxicológico e como ele é realizado, bem como seus tipos, aplicações e importância.
O que é um exame toxicológico:
Um exame toxicológico é uma análise laboratorial que busca detectar a presença de substâncias tóxicas no organismo, como drogas ilícitas, medicamentos controlados e outras substâncias químicas.
Essa análise é crucial para identificar o consumo recente ou frequente dessas substâncias, proporcionando informações importantes para diversas áreas, como segurança viária e saúde ocupacional.
Tipos de exames toxicológicos:
Existem diferentes tipos de exames toxicológicos, cada um com suas particularidades. Vamos explorar três dos principais:
Exame toxicológico de cabelo:
O exame de cabelo é um dos métodos mais eficazes para detectar substâncias tóxicas no organismo. Explicaremos como funciona a coleta da amostra de cabelo, os períodos de detecção e as vantagens e desvantagens dessa modalidade.
Exame toxicológico de urina:
O exame de urina é amplamente utilizado em diversos contextos, incluindo a detecção de drogas e substâncias tóxicas. Abordaremos como é realizado o exame de urina, suas limitações e suas aplicações práticas.
Exame toxicológico de saliva:
O exame de saliva é uma opção mais rápida e simples para a detecção de substâncias tóxicas. Veremos como funciona esse tipo de exame, suas vantagens e desvantagens em comparação com outros métodos.
Aplicações do exame toxicológico:
O exame toxicológico tem aplicações diversas em diferentes setores. Duas áreas de destaque são o uso do exame em motoristas profissionais e em ambientes de trabalho.
Uso do exame em motoristas profissionais:
Explicaremos as regulamentações que exigem o exame toxicológico para motoristas profissionais, como a renovação da CNH, e como isso contribui para a segurança viária, evitando que pessoas sob efeito de substâncias tóxicas assumam o volante.
Uso do exame em ambientes de trabalho:
Diversos setores demandam exames toxicológicos como medida de prevenção de acidentes e proteção dos funcionários. Abordaremos quais são esses setores, a importância do exame nesses contextos e como ele contribui para a segurança no trabalho.
Processo de análise do exame toxicológico:
Para compreender melhor o exame toxicológico, é importante conhecer as etapas envolvidas no processo de análise, como a coleta da amostra, o transporte e armazenamento adequados e a análise laboratorial propriamente dita.
Também discutiremos o tempo necessário para obter os resultados e os fatores que podem influenciar os resultados, como a frequência de uso das substâncias, o tipo de exame realizado e o metabolismo individual.
Processo de análise do exame toxicológico
Dependendo do tipo de exame toxicológico realizado, o tempo necessário para obter os resultados pode variar.
Além disso, é essencial compreender as etapas envolvidas no processo de análise do exame toxicológico. Vejamos algumas delas:
Coleta da amostra:
A primeira etapa consiste na coleta da amostra biológica, que pode ser cabelo, urina ou saliva, dependendo do tipo de exame. É importante seguir as instruções fornecidas pelo laboratório para garantir a integridade e a representatividade da amostra.
Preparo da amostra:
Após a coleta, a amostra precisa passar por um processo de preparo, que pode envolver a extração e o tratamento químico para concentrar as substâncias de interesse. Esse preparo é necessário para aumentar a sensibilidade e a precisão das análises.
Análise laboratorial:
A amostra preparada é submetida a análises laboratoriais específicas para identificar e quantificar as substâncias tóxicas presentes.
Métodos como cromatografia, espectrometria de massa e imunoensaio são comumente utilizados para detectar e confirmar a presença das substâncias.
Interpretação dos resultados:
Uma vez realizadas as análises, os resultados são interpretados por especialistas. Eles consideram os limites de detecção, os padrões de referência e outros critérios para determinar se as substâncias estão presentes e em qual quantidade.
Emissão do laudo:
Com base na análise dos resultados, o laboratório emite um laudo que descreve as substâncias detectadas, suas concentrações e quaisquer observações relevantes. Esse laudo é um documento oficial que fornece informações sobre o estado toxicológico da pessoa testada.
É importante ressaltar que o processo de análise do exame toxicológico requer equipamentos e técnicas sofisticadas, bem como profissionais capacitados.
Mitos e verdades sobre o exame toxicológico:
Ao longo dos anos, surgiram diversos mitos e informações incorretas relacionadas ao exame toxicológico. É importante desmistificar esses equívocos para que as pessoas tenham uma compreensão precisa e objetiva sobre o assunto.
A seguir, vamos abordar alguns dos mitos mais comuns e apresentar as verdades por trás deles:
- Mito: O exame toxicológico pode apresentar resultados falsos.
- Verdade: Quando realizado em laboratórios confiáveis e com metodologias corretas, o exame toxicológico é extremamente preciso e confiável. Os laboratórios utilizam técnicas avançadas e validadas para garantir a precisão dos resultados.
- Mito: É possível burlar o exame toxicológico usando métodos como xampu de limpeza capilar.
- Verdade: Métodos como xampus de limpeza capilar não são eficazes para enganar o exame toxicológico de cabelo. Esses produtos não conseguem remover completamente as substâncias tóxicas do cabelo e podem até comprometer a análise.
- Mito: O exame toxicológico pode identificar o uso de medicamentos controlados.
- Verdade: O exame toxicológico tem como objetivo principal detectar o uso de drogas ilícitas e substâncias tóxicas. Medicamentos controlados, quando utilizados de acordo com as prescrições médicas, geralmente não são identificados pelo exame toxicológico.
- Mito: O exame toxicológico pode detectar o uso de drogas por muito tempo após o consumo.
- Verdade: O período de detecção das substâncias no exame toxicológico varia de acordo com o tipo de exame e a substância em questão. No entanto, para a maioria das drogas, o período de detecção é limitado e varia de alguns dias a algumas semanas, dependendo do tipo de exame e da frequência de uso.
- Mito: O exame toxicológico é invasivo e desconfortável.
- Verdade: Os exames toxicológicos de cabelo, urina e saliva são simples e não invasivos. A coleta da amostra é geralmente indolor e não causa desconforto significativo para a pessoa sendo testada.
É importante lembrar que cada exame toxicológico possui suas próprias características e limitações. Consultar um profissional de saúde ou especialista em toxicologia pode ajudar a esclarecer qualquer dúvida ou preocupação específica relacionada ao exame.
Conclusão
O exame toxicológico é uma análise laboratorial crucial para detectar substâncias tóxicas no organismo humano.
Com diferentes tipos de exames disponíveis, como cabelo, urina e saliva, ele desempenha um papel fundamental na segurança viária, saúde ocupacional e prevenção de acidentes. É importante desmistificar os mitos e garantir a precisão dos resultados.
Consultar especialistas é fundamental para compreender suas aplicações e limitações.



